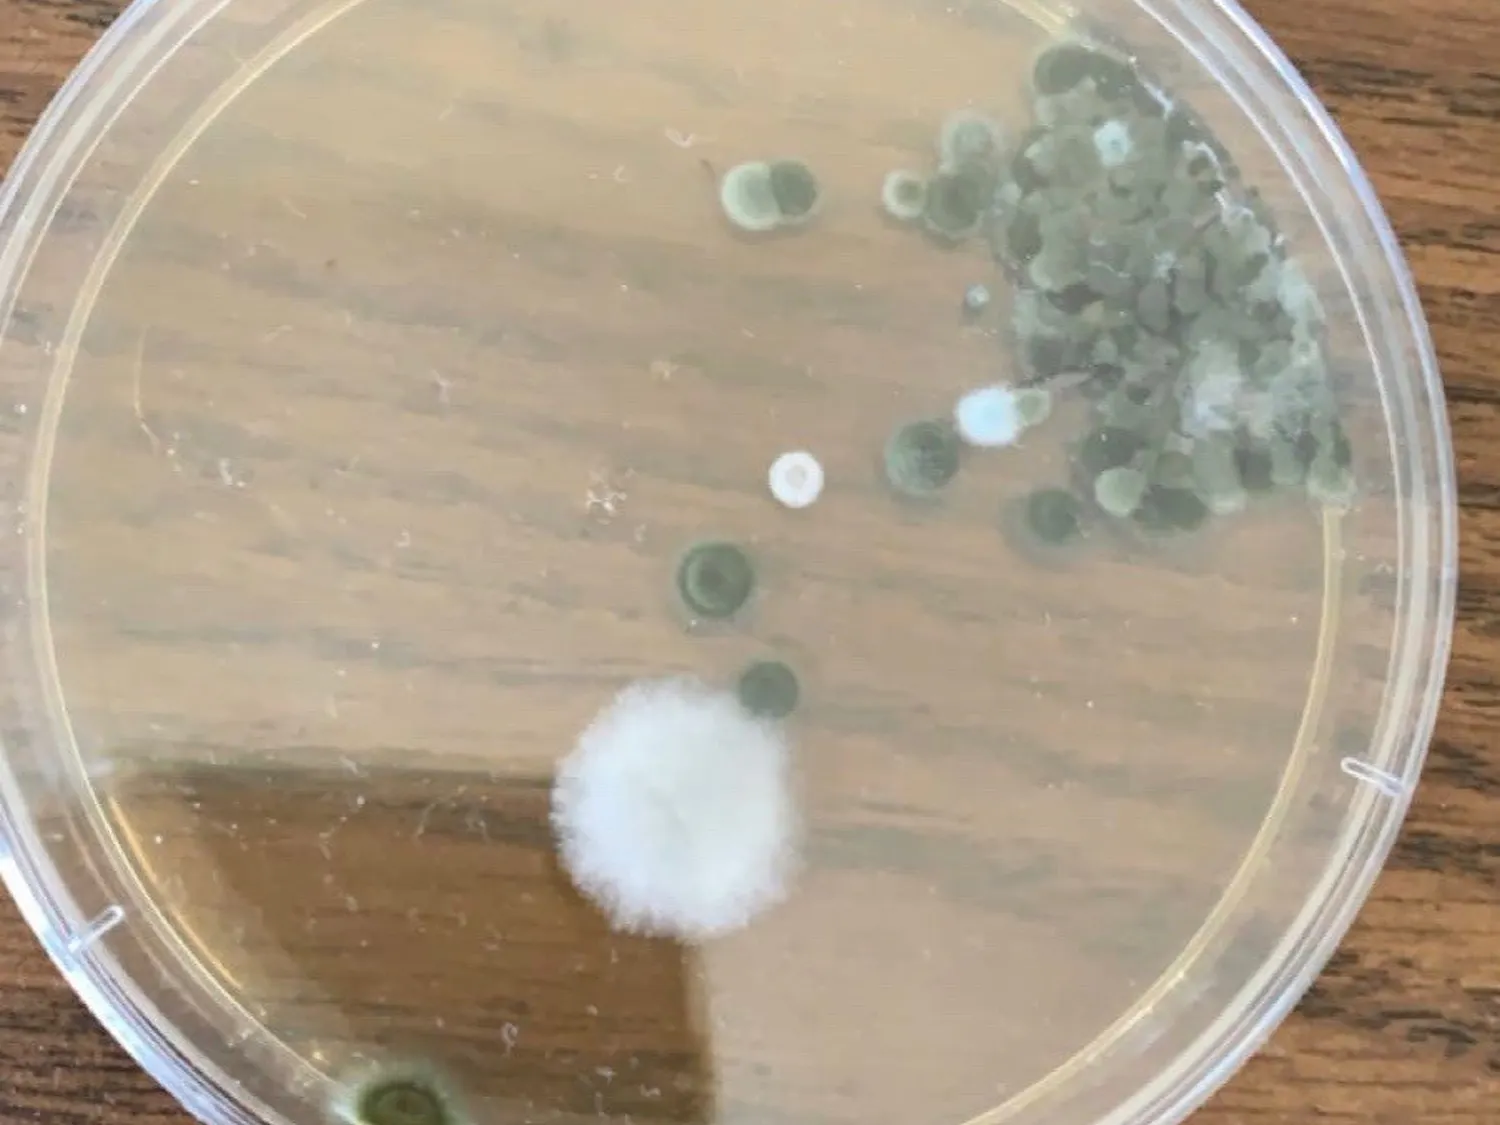
Black mold found in student's petrie dish

Send Silence Packing brings suicide awareness to campus
Grace Reynolds | November 5AUBURN, Ala. (EETV) - Over 1,000 backpacks were spread across the Student Center green space today to represent the number of students who die due to suicide each year.